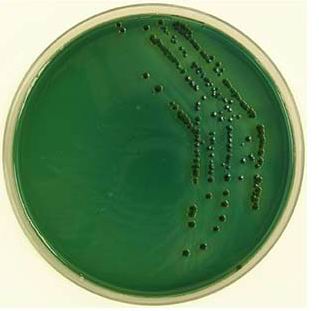

檢測認證人脈交流通訊錄
檢測認證人脈交流通訊錄
- 水產養殖常見的弧菌有:副溶血弧菌、溶藻弧菌、霍亂弧菌、鰻弧菌、哈維氏弧菌等。
TCBS培養基(弧菌培養基)上常見有三種顏色,分別為:
綠色——副溶血弧菌、河流弧菌;
黃色——溶藻弧菌、霍亂弧菌、哈維弧菌、鰻弧菌;
黑色——腸桿菌科(如沙門氏菌。因其能代謝產生的硫化物能和培養基里的鐵離子反應生成黑色物質)
養殖戶簡單地檢測弧菌,需要的最簡單的儀器和設備
???
名稱 規格型號 數量 估價(單價)
萬用電爐 泰斯特DK-98-II單聯 1臺 98.00
天平 0.1g, YP2001B 1臺 260.00 (不同廠家型號價格不同)
小型恒溫培養箱 25*25*25cm 鍍鋅鐵內膽 1臺 900.00 (另有不銹鋼內膽材質)
一次性無菌培養皿 90mm,10個/包,500個/箱 1箱 整箱400元,拆零10元/包
100ml量筒 100ml 亞速旺 1支 28.00
三角燒瓶 500ml 蜀牛 1個 16.00
燒杯 500ml 亞速旺 1個 12.00
無菌巴氏滴管 獨立包裝 每滴約50微升。 20支 100支以下0.8元/支
酒精燈 酒精需要另外購買 1個 8元
玻璃攪拌棒 2支 3元/支
玻璃涂布棒 若干 3元/支
一次性無菌L型涂布棒 10支/包 20支 8元/包 (獨立包裝的1元/支)
一次性無菌接種環 一次性使用 5支 1元/支
優質接種環+接種棒 接種環可使用上千次。 1支 50元
TCBS培養基 陸橋 250克/瓶 1瓶 130元/瓶
無菌采樣瓶 100ml ,按采樣數 若干 3元/個
可滅菌采樣瓶60ml PP材質,可高壓滅菌 若干 5元/個
我公司供應以上弧菌檢測儀器設備及培養基耗材等產品。
女人十八毛片嫩草av|
女人黄色一级片|
日av中文字幕|
天堂av资源网|
美女网站免费观看视频|
性xxxx视频播放免费|
国产v亚洲v天堂无码久久久
|
日韩精品一区二区三区不卡
|
国产精品成人免费一区久久羞羞|
欧美色图另类小说|
91丨porny丨九色|
中文字幕久久av|
美女100%无挡|
中文字幕xxxx|
欧美一级欧美一级|
日韩一区二区三区在线观看视频|
午夜激情在线观看视频|
亚洲欧美日本一区|
中文字幕在线看人|
黄色a级片免费看|
免费av网站在线播放|
国内自拍视频网|
国产女主播喷水高潮网红在线|
日操夜操天天操|
朝桐光av在线|
精品人妻少妇嫩草av无码专区|
久久精品99国产|
www.中文字幕av|
中文字幕乱码中文字幕|
国产3p露脸普通话对白|
久久久久久婷婷|
手机在线看片1024|
黄色一级片播放|
三级男人添奶爽爽爽视频|
日韩欧美亚洲一区二区三区|
中文字幕av久久爽av|
黄色片网站免费在线观看|
免费黄频在线观看|
亚洲综合激情五月|
国产精品91av|
国产熟妇一区二区三区四区|
亚洲 高清 成人 动漫|
www.免费av|
一区二区三区免费在线视频|
熟妇人妻va精品中文字幕|
国产午夜精品久久久久久久久|
国产精品久久久久精|
美女在线视频一区二区|
黄频视频在线观看|
精品国产免费久久久久久婷婷|
日本污视频网站|
国产女人18毛片水真多|
97超碰成人在线|
午夜免费激情视频|
岛国精品一区二区三区|
91视频在线视频|
中文字幕av专区|
毛片av在线播放|
色无极影院亚洲|
亚洲国产精品suv|
日本a在线观看|
日本韩国欧美在线观看|
免费看的黄色录像|
久久久久亚洲av无码专区首jn|
亚洲精品www久久久久久|
免费超爽大片黄|
国产视频不卡在线|
神马久久久久久久久久|
日韩 欧美 中文|
中文字幕视频三区|
无罩大乳的熟妇正在播放|
久久久精品成人|
中文字幕第3页|
www.com欧美|
波多野结衣一二区|
麻豆疯狂做受xxxx高潮视频|
国产91免费在线观看|
91看片在线播放|
五月婷婷六月丁香激情|
欧美精品久久久久久久久久久|
欧美a级片免费看|
黄色网址在线视频|
天天操天天干天天插|
中文字幕 视频一区|
国产在线一区视频|
五月天亚洲视频|
日本www在线播放|
激情视频小说图片|
黄色录像免费观看|
国产精品美女高潮无套|
无码国产69精品久久久久网站|
好吊视频一区二区三区|
国产精品一区二区人人爽|
亚洲GV成人无码久久精品|
久久久久成人精品无码|
国产女同无遮挡互慰高潮91|
日韩毛片在线免费看|
伊人成色综合网|
欧美黑人经典片免费观看|
一级特黄妇女高潮|
天天在线免费视频|
天天爱天天做天天操|
亚洲欧美一二三区|
美日韩一二三区|
97超碰人人干|
在线观看日韩中文字幕|
黄色小说在线观看视频|
国产主播在线播放|
伊人久久综合视频|
av大片免费观看|
日日噜噜噜噜人人爽亚洲精品|
日产欧产va高清|
久久草视频在线|
日本熟女毛茸茸|
99久久久无码国产精品免费蜜柚|
国产手机在线视频|
中文字幕视频网站|
日本精品入口免费视频|
中文字幕第99页|
国产女人18毛片水18精|
成人乱码一区二区三区|
人妻丰满熟妇av无码区hd|
日本精品一区二区在线观看|
天天操天天干天天插|
日本少妇一级片|
麻豆国产精品一区|
国产wwwwxxxx|
中文字幕色呦呦|
丰满少妇被猛烈进入高清播放|
成年人免费大片|
午夜影院免费版|
国产情侣在线视频|
亚洲午夜激情视频|
日韩永久免费视频|
欧美精品黑人猛交高潮|
国产成人精品视频免费|
午夜啪啪福利视频|
欧美日韩在线视频一区二区三区|
www.com黄色片|
日韩免费视频网站|
国产视频第二页|
韩国一区二区三区四区|
亚洲激情视频小说|
国产精品一二三在线观看|
国产欧美日韩网站|
在线观看免费不卡av|
日本在线观看视频网站|
亚洲无码久久久久|
久久精品aⅴ无码中文字字幕重口|
日本黄色特级片|
国产成人免费高清视频|
无码国产精品一区二区免费16|
欧美无人区码suv|
色老板免费视频|
国产在线精品91|
久久高清无码视频|
国产一区二区视频免费观看|
婷婷在线免费观看|
亚洲AV成人无码网站天堂久久|
精品国产av无码一区二区三区|
欧美日韩一区二区三区69堂|
天天操夜夜操视频|
视频污在线观看|
少妇视频一区二区|
久久综合久久色|
免费黄色网址在线|
亚洲av成人无码久久精品老人|
日本黄区免费视频观看|
国产一区二区三区精彩视频|
五月激情六月丁香|
精品国产午夜福利在线观看|
182在线观看视频|
www.亚洲高清|
国产乱淫a∨片免费观看|
丰满少妇在线观看资源站|
黄色成人在线免费观看|
国产一级做a爰片在线看免费|
精品国产va久久久久久久|
免费黄在线观看|
91极品视频在线观看|
在线视频1卡二卡三卡|
久久无码人妻精品一区二区三区
|
青青草华人在线视频|
粉嫩虎白女毛片人体|
最近中文字幕在线观看|
特级西西人体wwwww|
91成人在线观看喷潮教学|
亚洲婷婷综合网|
黄色av网址在线观看|
国产深夜男女无套内射|
在线免费观看国产精品|
亚洲av无码一区二区三区网址|
国产精品免费无遮挡无码永久视频|
亚洲xxxx3d动漫|
亚洲精品中文字幕乱码无线|
亚洲av综合色区无码一区爱av
|
三级在线观看网站|
中文字幕一区二区三区四区五区人
|
黄色激情在线观看|
福利视频一二区|
中文字幕一区二区久久人妻|
摸摸摸bbb毛毛毛片|
超碰人人草人人|
麻豆网站免费观看|
久操网在线观看|
夜夜躁很很躁日日躁麻豆|
亚洲少妇xxx|
日本一二三区不卡|
国产美女喷水视频|
色黄视频免费看|
中国极品少妇xxxx|
一区二区成人网|
日韩中文字幕观看|
黄色影院一级片|
精品人妻一区二区三区换脸明星
|
日日噜噜噜噜久久久精品毛片|
风流少妇一区二区三区91|
久久成人福利视频|
国产成人精品一区二三区四区五区|
国产又爽又黄ai换脸|
永久免费无码av网站在线观看|
五月天婷婷丁香网|
国产成人精品网|
一本一本久久a久久|
天堂中文在线网|
黄色激情小视频|
午夜久久久久久久久久影院|
日韩亚洲欧美中文字幕|
黑人精品无码一区二区三区AV|
国产精品视频看看|
国产又粗又猛又爽又|
男女激烈动态图|
国产99对白在线播放|
亚洲熟妇无码一区二区三区导航|
亚洲精品久久久蜜桃动漫|
欧美 日本 亚洲|
中文字幕av一区二区三区人妻少妇|
福利在线一区二区三区|
yy1111111|
精品美女久久久久|
91免费视频黄|
亚洲第一视频在线|
黄色国产小视频|
亚洲av无码一区二区二三区|
国产乡下妇女做爰|
波多野结衣毛片|
99re6这里有精品热视频|
精品国产99久久久久久宅男i|
成人免费毛片网|
久久人人爽人人人人片|
日韩一区二区视频在线|
国产精品8888|
日日夜夜精品免费|
久久人人爽人人片|
成人涩涩小片视频日本|
国产精品高潮呻吟AV无码|
免费在线观看的av网站|
日韩人妻一区二区三区|
无码人妻一区二区三区免费
|
国产成人一区二区在线观看|
无码日韩精品一区二区|
www.爱色av.com|
一二三不卡视频|
最新在线中文字幕|
69堂免费视频|
91网站免费视频|
91丨九色丨丰满|
中文字幕中文在线|
五月天男人天堂|
欧美69精品久久久久久不卡|
精品美女久久久久|
每日在线更新av|
少妇无套高潮一二三区|
av网站在线免费看|
国产亚洲精品成人|
亚洲精品久久久久久久蜜桃臀|
91精品又粗又猛又爽|
亚洲精品久久久久久久蜜桃|
国产精品igao|
人妻人人澡人人添人人爽|
亚洲 自拍 另类 欧美 丝袜|
日韩av大片在线观看|
欧美一级片中文字幕|
婷婷社区五月天|
日本女人性视频|
一区二区www|
免费人成在线观看|
欧日韩免费视频|
99久久久无码国产精品不卡|
手机av在线免费观看|
日日噜噜噜噜人人爽亚洲精品|
热久久精品免费视频|
中文字幕影音先锋|
在线观看国产免费视频|
精品国自产在线观看|
av中文在线播放|
中文字幕成人免费视频|
日韩专区第三页|
国产精品无码无卡无需播放器|
无码国产精品一区二区高潮|
最近中文字幕免费观看|
久久婷婷综合国产|
男女无套免费视频网站动漫|
色香蕉在线观看|
极品蜜桃臀肥臀-x88av|
亚洲天堂国产视频|
久久久亚洲精品无码|
日韩一级片大全|
素人fc2av清纯18岁|
人妻丰满熟妇av无码区hd|
伊人久久一区二区|
国产成人精品一区二三区|
天天操狠狠操夜夜操|
玩弄中年熟妇正在播放|
国产88在线观看入口|
久操视频在线观看免费|
91丝袜在线观看|
亚洲aⅴ在线观看|
亚洲精品综合网|
国产又粗又猛视频|
jizz国产在线观看|
av大片在线免费观看|
久艹视频在线观看|
五月天视频在线观看|
亚洲精品乱码久久久久久自慰|
又大又硬又爽免费视频|
182在线观看视频|
eeuss中文字幕|
www.黄色在线|
国产免费看av|
国产精品无码午夜福利|
女同性恋一区二区三区|
一级全黄裸体片|
91人妻一区二区|
国产精品熟女一区二区不卡|
天堂在线视频免费|
日本激情视频网站|
天堂中文网在线|
好吊视频一二三区|
手机看片一区二区|
手机看片1024日韩|
老司机av网站|
精品影片一区二区入口|
久久久老熟女一区二区三区91|
在线看黄色的网站|
91丨porny丨对白|
亚洲最大的黄色网|
免费人成又黄又爽又色|
国产精品久久久久无码av色戒|
精品人妻无码一区|
久久久99999|
无码人妻aⅴ一区二区三区日本|
91精品国产毛片武则天|
青青草国产精品视频|
国产成人无码一二三区视频|
午夜免费一区二区|
超碰在线资源站|
国产精品1000|
四虎影院在线免费播放|
在线视频播放大全|
黄色成人一级片|
91成人在线观看喷潮蘑菇|
亚洲av片不卡无码久久|
国产亚洲精品精品精品|
国产精品九九九九九九|
日本午夜激情视频|
国产3p在线播放|
国产乡下妇女做爰|
亚洲天堂网在线视频|
亚洲精品福利网站|
五月天丁香社区|
超碰人人干人人|
国产精品自产拍|
亚洲男人第一天堂|
日本三级日本三级日本三级极|
在线视频第一页|
国产乱子伦精品视频|
777米奇影视第四色|
青青草在线观看视频|
国产精华7777777|
亚洲 另类 春色 国产|
国产国语性生话播放|
蜜臀久久精品久久久用户群体|
国产av熟女一区二区三区|
四季av一区二区|
国产一级片毛片|
www.爱爱.com|
国产精久久一区二区三区|
特一级黄色录像|
狠狠热免费视频|
东京热一区二区三区四区|
国精产品一品二品国精品69xx|
伊人网在线视频观看|
欧美极品少妇无套实战|
加勒比av中文字幕|
夜夜嗨av禁果av粉嫩avhd|
国产精品19p|
91免费网站视频|
天堂av8在线|
国产毛片在线视频|
 檢測認證人脈交流通訊錄
檢測認證人脈交流通訊錄